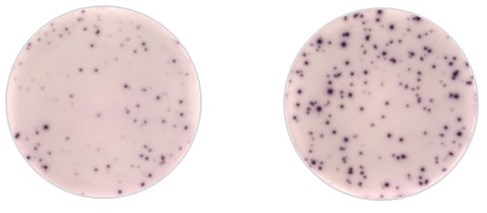
ELISPOT

AAV Capsid Immunology

Why study AAV Capsid Immunology?
Adeno-associated virus (AAV) viral vectors have many attractive features including a large tropism and the ability to transduce quiescent cells. Moreover, those viral vectors are able to sustain permanent gene expression after one single in vivo administration. However, untoward immune responses to the viral capsid and/or transgene products have emerged as serious obstacles for successful clinical translation.
AAV-based gene transfer usually results in neutralizing antibody responses and T cell responses. While the humoral response has been successfully recapitulated in animal models and follows a relatively classic and predictable pattern in the clinical setting; T-cell responses in humans have not been predicted by animal models and are still poorly understood.
Research Interests
Several factors could influence the initiation of immune responses to the AAV vector and/or the transgene product including the dose, the AAV serotype or the mode of vector delivery. Because our lab is developing therapeutic strategies targeting the muscle and the central nervous system in mice, non-human primates and humans, it is important to analyze the immune responses to AAV capsid and/or the transgene product in each model. We routinely perform neutralizing antibody assays and ELISAs to detect the humoral immune response and ELISpot and intracellular cytokine stainings (ICS) to characterize the cellular immune response.
These images show IFNγ-ELISpot response to AAV1 capsid in AAT deficient-patient treated by gene therapy. On the left is the patient peripheral blood mononuclear cells (PBMCs) IFNγ positive response to AAV1 peptides. On the right is the patient PBMCs restimulated with CEFT peptides used as a positive control.
Regarding the specific T cell response to AAV capsid, our lab showed that intramuscular delivery of rAAV1 in humans induces a tolerogenic response to rAAV capsid characterized by regulatory T cell infiltration at the site of injection and lead to stable expression in patients for more than 5 years. We are currently working on the characterization of tolerance mechanism induced by this mode of delivery in non-human primates and humans. In this research area we are partnering with Dr. Terence Flotte. You can visit his website here.
Let's have the next breakthrough together!
